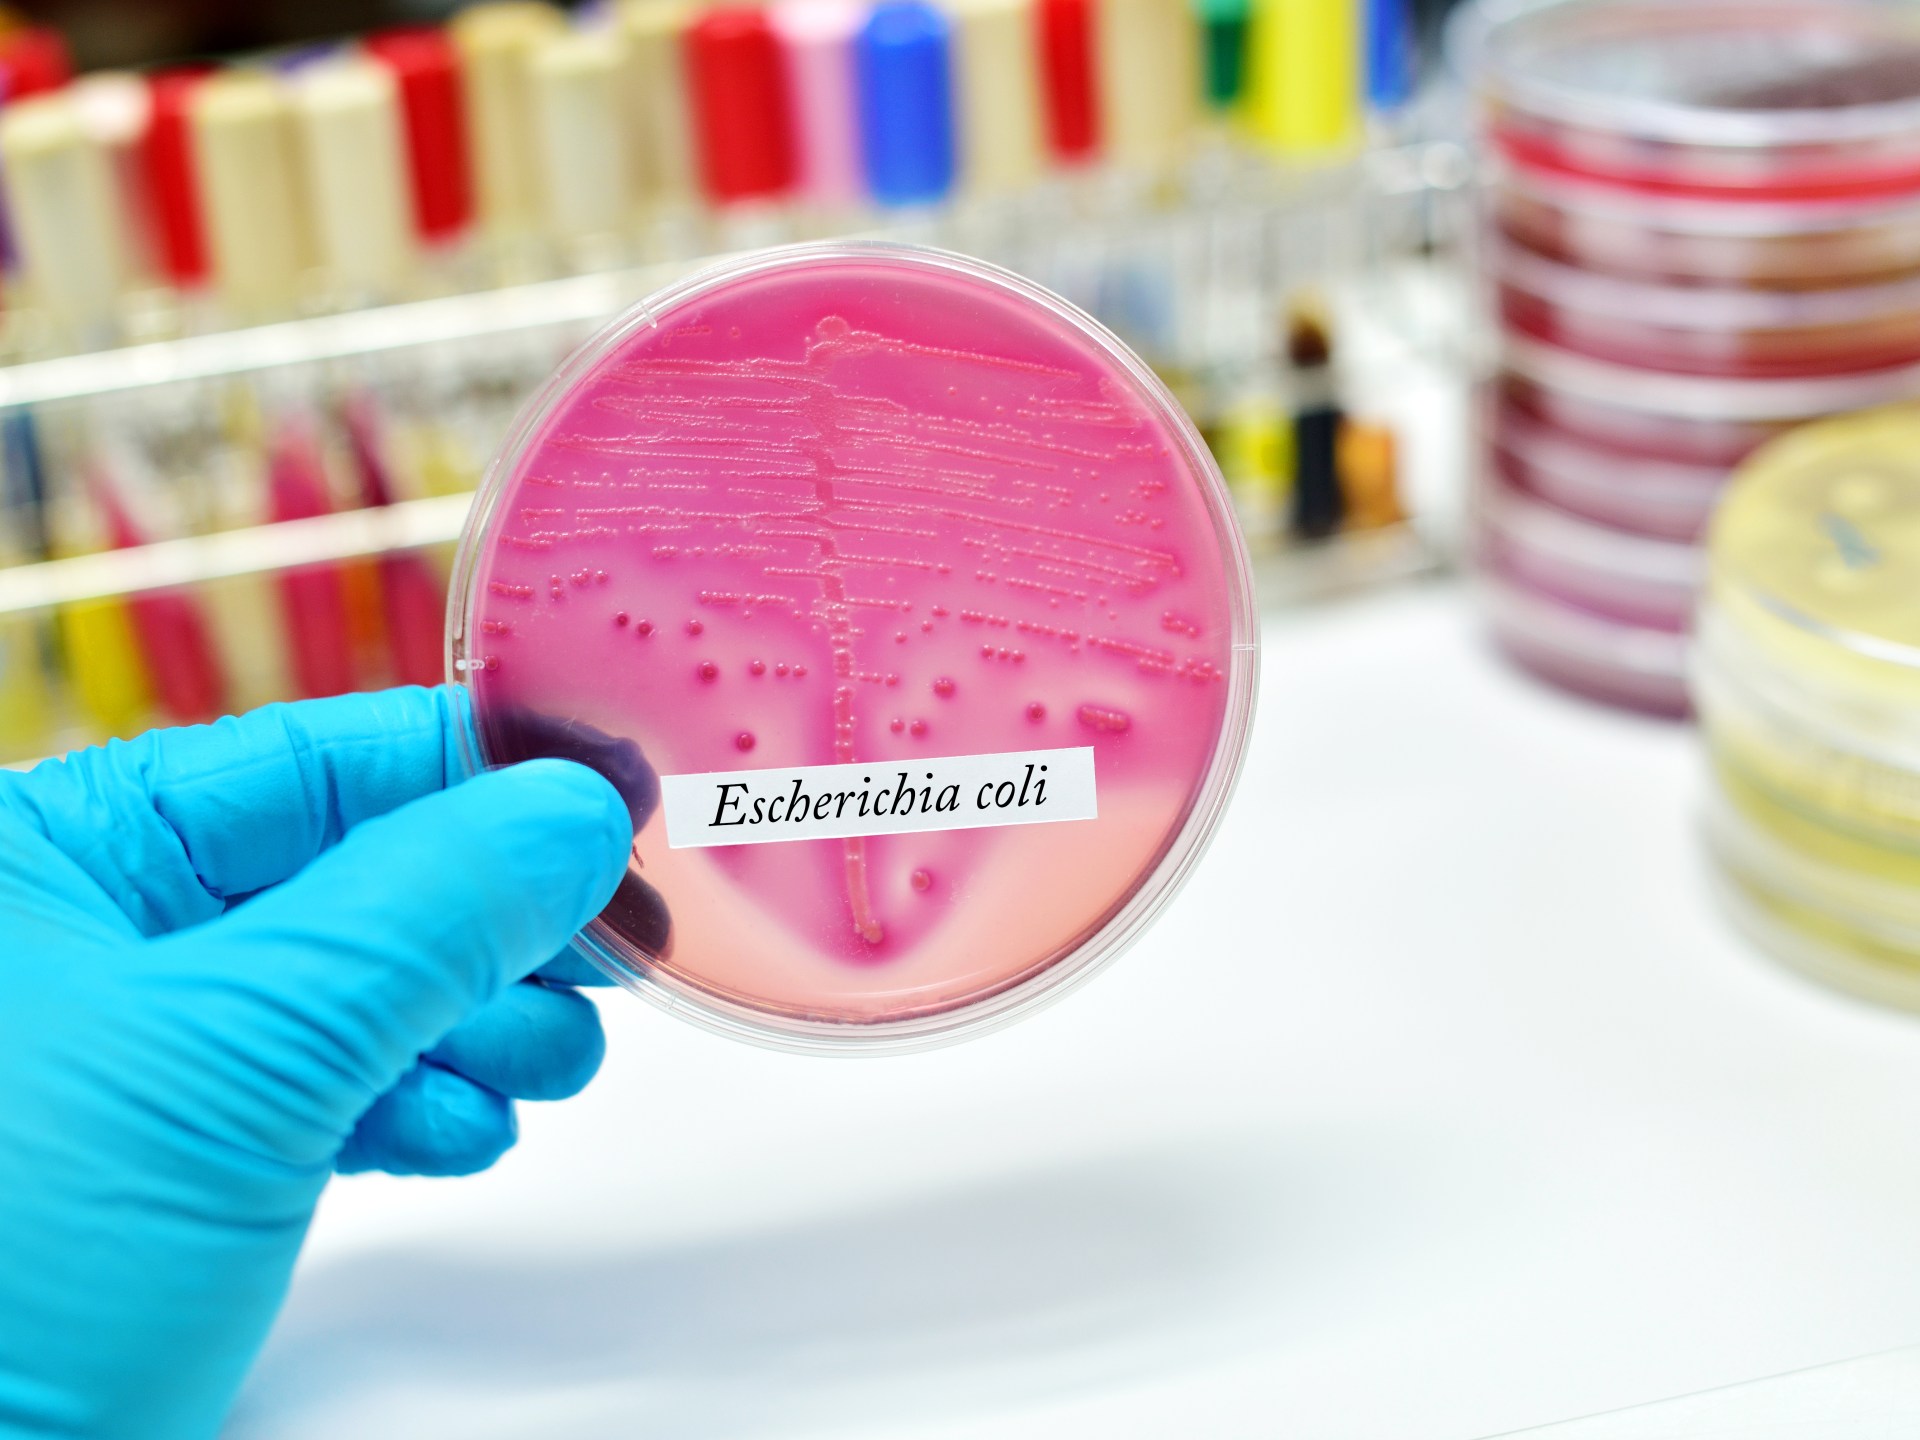
Study: Addressing strains of E. coli bacteria reduces the risk of cancer

Targeting specific strains of E. coli bacteria with vaccines or other treatments could help reduce the risk of bowel, bladder and prostate cancers, scientists said.
This comes as a study indicated that the high number of certain cancers in industrialized countries such as the United Kingdom may be linked to two specific types of E. coli that can cause infections in the urinary tract and bloodstream, according to the British News Agency (PA Media).
These strains produce a DNA-damaging chemical called colibactin, which has been linked to bowel cancer.
Scientists said that working to eliminate them “could have significant public health benefits”, including reducing the need for antibiotics to treat the infections they cause and potentially reducing the risk of cancer.
It is noteworthy that “E. coli” is a diverse group of bacteria that are usually harmless and live in the intestines of humans and animals.
For the study, published in the journal Lancet Microbe, researchers used genetic surveillance to track down the different strains across different countries including the United Kingdom, Norway, Pakistan and Bangladesh.
The two strains that the researchers focused on are the most common in industrialized countries, and cause infections in the bloodstream and urinary tract more than food poisoning.
The researchers said that these countries have high levels of bowel, bladder and prostate cancers.
On the other hand, the team’s analysis showed that the two strains are rarer in countries such as Bangladesh and Pakistan, where the incidence of bowel, bladder and prostate cancers is also lower.